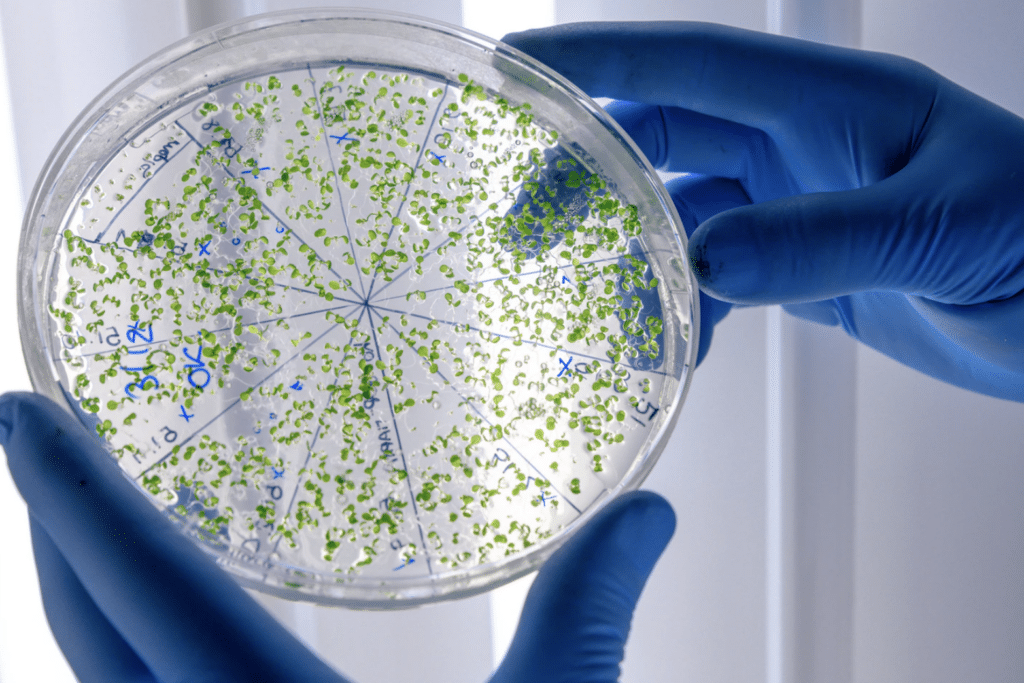

Going to college is more than just earning a degree. The value of your major will determine and boost your earning potential. To make sure that you get the most out of your college degree, it is essential to choose a major that is not only aligned with your interests but is also valued in current times. Confused about where to start? We have compiled a list of the 35 Highest Paying Majors to get you started.
How to Choose a College Major?
Some students know exactly what they want to study in college and eventually pursue as a career. Others explore different options before finalizing a major. There are plenty of factors to consider when choosing a major:
1. Before deciding on a major, decide on an aptitude
While you certainly can achieve anything you put your mind to, it is better to maximize your strengths and select a major in which you have an interest and is better aligned with your knowledge and skills. Think beyond your academic work.
2. Consider the earning potential
The demand for certain majors is more than others, and so is their value. The intensive coursework of certain majors pays more than others, provided that there is a consistent demand for it in the industry/market.
3. Research the course requirements
Course requirements can also be a dealbreaker when selecting a college major. You may have an aptitude for a subject, but may not be the best fit for the course requirements of some majors. The duration of the major and how quickly you will be able to transition into it practically and professionally matters.
It is also possible that you may require other certifications/qualifications to succeed in a particular field.
4. Ask the important questions
Will the major you choose be enough to sustain you for the rest of your life? Will there always be opportunities and job prospects for you in this field? What does the growth of your career look like by pursuing a certain degree? You should know the answers to all of these questions.
35 Highest Paying Majors
1. Petroleum Engineering

Median Base Salary: $187,300
Popular Entry-Level Jobs: Drilling Engineer, Production Engineer, Reservoir Engineer
Petroleum Engineering tops our list of the highest-paying majors. This field will appeal to students who are interested in science and engineering, and are passionate about developing new methods of extracting natural resources from the earth. You’ll be studying a range of science and mathematical subjects throughout this degree. Related degrees include civil, mechanical, and chemical engineering.
2. Computer & Information Sciences

Median Base Salary: $140,900
Popular Entry-Level Jobs: Web Developer, Software Engineer, Systems Engineer
Computer and Information Sciences students innovate and design new ways to use computing technology, as well as maintain existing technologies. A high demand exists for experts in the field of computers to develop, test, and maintain the implementation of computer applications.
3. Pharmacology & Toxicology

Median Base Salary: $138,700
Popular Entry-Level Jobs: Cell/Molecular Biologist, Clinical Researcher, Consultant, Forensic Scientist / Toxicologist
As a subsidiary of biomedical science, Pharmacology studies chemical drugs and their effect on humans and organisms. Pharmacologists and Toxicologists are responsible for developing drugs for safely dispensing to patients. There has been significant growth in the demand for this major in the past couple of years; due to an increase in the study of cell therapies and the development of vaccines.
4. Chemical Engineering

Median Base Salary: $135,900
Popular Entry-Level Jobs: Chemical Engineer, Process Engineer, Project Engineer
Chemical Engineering involves designing, producing, transporting, operating, and transforming intensive industrial processes that take raw materials as input and turn them into valuable products as outputs. Students with a passion for experimentation and an aptitude for natural sciences such as chemistry, physics, and biology will benefit most from this degree.
5. Actuarial Science

Median Base Salary: $134,400
Popular Entry-Level Jobs: Actuarial Assistants, Associate Actuaries, Actuarial Trainees
Every business has some risk involved, and actuarial sciences develop the understanding of risk to evaluate and make the best decisions. Students of Actuarial Sciences will be studying mathematics, finance, statistics, and risk management. Interested students should have strong math skills geared towards the business side.
6. Computer Engineering

Median Base Salary: $131,000
Popular Entry-Level Jobs: Computer Vision Engineer, Trainee Software Developer, Software Quality Assurance Engineer
Computer Engineering combines computer sciences and electrical engineering to cater to both the hardware and software of technology. Computer engineering students can expect to learn the design of computer architecture and systems as well as its software development.
7. Nuclear Engineering

Median Base Salary: $129,400
Popular Entry-Level Jobs: Instrumentation & Controls Engineer, Entry-Level Mechanical Engineer, Nuclear Engineer Associate
Nuclear Engineering is among the highest-paying and in-demand careers out of college. Specialization in this field involves in-depth research and development to create the methodology, processes, and tools to harness and utilize nuclear energy. Nuclear engineers may delve into the medical field to research radiation treatments and develop the safety protocol for nuclear management.
8. Electrical Engineering

Median Base Salary: $125,800
Popular Entry-Level Jobs: Electrical Engineer, Systems Engineer, Software Developer
The field of Electrical Engineering involves the design, development, application, and maintenance of the devices and equipment that function with electricity and electromagnetism.
9. Astronomy & Astrophysics

Median Base Salary: $125,400
Popular Entry-Level Jobs: Research Scientist, Physicist, Aerospace Engineer
Students with an interest in energy and matter will enjoy pursuing Astronomy & Astrophysics as a major. Future opportunities include progressing scientific research in research laboratories, and observatories.
10. Applied Mathematics

Median Base Salary: $122,000
Popular Entry-Level Jobs: Math Teacher, Software Engineer, Data Analyst
A degree in Applied Mathematics can be used to solve problems in other fields such as engineering, physics, science, biology, business, finance, and industry, making it one of the highest-paid degrees.
11. Aerospace, Aeronautical, & Astronautical Engineering

Median Base Salary: $121,200
Popular Entry-Level Jobs: Structural Design Engineer, Propulsion Engineer, Aerodynamics Engineer
Another sought-after and well-paid college major is Aerospace Engineering. Students pursuing this as a career will be tasked with the design and development of prototypes and functioning units of spacecraft and other aircraft.
12. Physics

Median Base Salary: $119,700
Popular Entry-Level Jobs: Physicist, Research Fellow, Computer Programmer
Physics is a branch of natural sciences in which students study the fundamentals of matter and motion with respect to time and space, and related forces and energies.
13. Industrial Engineering

Median Base Salary: $117,400
Popular Entry-Level Jobs: Industrial Engineer, Quality Engineer, Production Planner
Industrial Engineering is a specialization dealing with the improved production and manufacturing of consumer and industrial goods. Students will also learn how to eliminate wasteful produce and scale industrial processes to make them more efficient. This field of engineering overlaps with Supply Chain.
14. Economics

Median Base Salary: $115,700
Popular Entry-Level Jobs: Financial Analyst, Management Analyst, Accountant
As a subsidiary of social sciences, economics is the study of the consumption of goods and services, and how economic factors and agents impact the consumption pattern. If you are a student who is interested in how economies work, this major is recommended.
14. Pharmaceutical Sciences & Administration

Median Base Salary: $115,700
Popular Entry-Level Jobs: Pharmaceutical Product Tester, Clinical Research Associate, Clinical Data Coordinator
Commonly confused with Pharmacy, Pharmaceutical Sciences & Administration is a combination of chemistry, biology, and toxicology to develop and administer medicine to living organisms.
16. Materials Engineering

Median Base Salary: $115,200
Popular Entry-Level Jobs: Ceramic Engineers, Metallurgical Engineers, Composites Engineers
Also known as Materials Science, this division of engineering entails the discovery and design of new materials. You’ll be exploring materials and understanding how they work by studying physics, math, and chemistry subjects.
17. Civil Engineering

Median Base Salary: $109,000
Popular Entry-Level Jobs: Civil Engineer, Structural Engineer, Field Engineer
Another popular and high-paying engineering career is civil engineering; handling the construction and maintenance of structures such as roads, dams, bridges, canals, airports, pipelines, and the foundations of buildings and railways.
18. Mathematics

Median Base Salary: $108,700
Popular Entry-Level Jobs: Drilling Engineer, Production Engineer, Reservoir Engineer
A degree in pure mathematics will be useful in countless jobs ranging from teaching to finance. Students who love numbers will enjoy the theory and application of mathematics in all spheres of life.
19. Construction Management

Median Base Salary: $108,000
Popular Entry-Level Jobs: Equipment Operator, Estimator, Project Manager
The reins of a construction project are held by construction management professionals. From the start of the project — preparing cost estimates, budgets, and scheduling, to the end of the project, everything is managed and finalized by construction management professionals. Students pursuing this major should expect on-site practical experience, learn the delegation of duties to required specialists, and adhere to the rules and regulations of building and safety codes, contract management, and legal regulations.
20. Finance

Median Base Salary: $105,200
Popular Entry-Level Jobs: Financial Analyst, Investment Banking Analyst, Accountant
Finance is the study of the management of funds by people and businesses. The discipline is often combined with Accounting, and learning Finance enriches students with a vast understanding of money. This course is part of the highest paying undergraduate degrees.
21. Genetics

Median Base Salary: $104,100
Popular Entry-Level Jobs: Molecular Genetics Lab Technologist, Laboratory Technologist Trainee, Electrolyte Scientist
Traits, qualities, heredity, and genes — students will enter the world of DNA by pursuing a degree in genetics.
21. International Business

Median Base Salary: $104,100
Popular Entry-Level Jobs: Bilingual Sales Representative, Business Engagement Trainee, Foreign Trade Zone Administrator
International Business is an interdisciplinary major that combines economics, business, trade, and other areas to prepare students for careers in global banks, corporations, and governments.
23. Agricultural Engineering

Median Base Salary: $104,000
Popular Entry-Level Jobs: Jr. Field Engineer, Controls Engineer, Associate Field Engineer
Another engineering degree on our list is agricultural engineering; the study of agriculture and the facilities and machinery that can be efficiently used to tackle environmental issues, and the processing and storage of agricultural products.
24. Operations Management & supervision

Median Base Salary: $103,000
Popular Entry-Level Jobs: Operations Administrative Assistant, Business Operations Intern, Strategy & Operations Officer
Operations management is concerned with overlooking business practices and day-to-day operations to maximize efficiency within an organization. From planning and organizing to implementing and evaluating the results for future planning, balancing the processes in a cost-effective manner to maximize profits is achieved through this discipline.
25. Labor & Industrial Relations

Median Base Salary: $100,600
Popular Entry-Level Jobs: Human Resources Employee Relations Analyst, Platform Analyst, Academic Personnel Analyst
Labor relations involve studying the complex relationship between employers and employees, and related dynamics such as labor unions, the law, and other employment instruments.
26. Veterinary Medicine

Median Base Salary: $100,370
Popular Entry-Level Jobs: Licensed Veterinary Technician, Licensed Veterinary Technician, Pet Care Attendant
Becoming a veterinarian is the go-to dream job for kids, but it is more than just petting cute animals. Veterinary care involves studying and understanding the proper administration of medicine for animals, as well as researching factors that are becoming growing concerns for the animal population.
27. Biochemistry

Median Base Salary: $99,900
Popular Entry-Level Jobs: Research Technician, Pharmacy Technician, Chemist
Studying biochemistry means studying life and organisms at a molecular level. A core subject for building knowledge of science, biochemistry opens doors to medicine, biotech, research, and more.
28. Information Science

Median Base Salary: $99,500
Popular Entry-Level Jobs: IT Technician, Systems Administrator, Database Administrator
Also known as information studies, information science is an academic field concerned with the collection, classification, analysis, storage, movement, and protection of information.
29. Public Administration

Median Base Salary: $99,290
Popular Entry-Level Jobs: Policy Analyst, Program Associate, Specialist, Government Affairs
Students who desire to become officials and leaders to serve communities should consider public administration as a degree. You’ll be learning all the necessary skills to manage matters at all levels of government — local, state, and federal.
30. Logistics, Materials, & supply Chain Management

Median Base Salary: $98,300
Popular Entry-Level Jobs: Logistics Technician, Production Scheduler, Warehouse Supervisor
Supply chain is a vast field with countless opportunities. It deals with the flow of goods and services between businesses over different geographical regions. Procurement of raw materials, their availability, storage as inventory, and distribution as finished goods to fulfill orders are all under supply chain management.
31. Physical therapy

Median Base Salary: $98,200
Popular Entry-Level Jobs: Athletic Trainer, Junior Physical Therapist
Physical therapy is a medical profession that promotes, maintains, and restores a healthy physique for humans. Other than understanding the human body and its mobility, students will also learn how to diagnose, treat and rehabilitate patients to prevent diseases and promote a healthy active lifestyle.
32. Robotics & Automation Engineering

Median Base Salary: $98,000
Popular Entry-Level Jobs: Automation / Controls Engineer, Software Engineer, Entry-Level Automation Specialist
They say AI is the future. Automation and robotics are very popular these days, so students interested in researching, designing, and creating robotics, and testing and automating processes should consider pursuing a career in robotics & automation engineering.
33. Marketing

Median Base Salary: $96,600
Popular Entry-Level Jobs: Marketing Coordinator, Account Executive, Marketing Analyst
Considered one of the highest-paying business degrees, majoring in marketing will cover everything needed to market a product or service, including branding, promotion, targeting audiences, and consumer behavior.
34. Industrial & Product Design

Median Base Salary: $95,900
Popular Entry-Level Jobs: Design Researcher, Packaging Designer, Product Designer
If creating blueprints and detailed designs for products interests you, consider a degree in industrial and product design. Beyond creating designs, specialists will be providing user interface(UI) and user experience(UX) solutions to manufacturers and their customers.
35. Microbiological Sciences & Immunology
Median Base Salary: $95,400
Popular Entry-Level Jobs: Quality Control Analyst, Clinical Microbiologist, Fermentation Technologist
A degree in microbiological sciences and immunology programs will cover unicellular organisms, genetic matter, and ecological interactions between humans and other organisms.